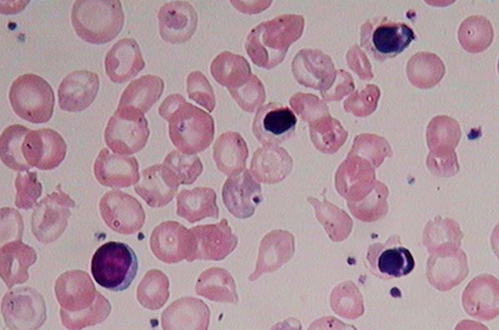
p>血细胞分析是一种通过一些 a href="#" data-lemmaid="1025692">

血细胞分析

血细胞分析报告怎么看
图片尺寸1154x866
血细胞分析.jpg
图片尺寸2177x1552
有看懂小婴儿血细胞分析的大佬吗?
图片尺寸1080x1439
一滴血检测活血形态分析图
图片尺寸1200x1600
中医医院血细胞分析检验报告单
图片尺寸805x369
血细胞分析检验单看不懂,谁能帮忙解释一下呢,谢谢了,男 ,25岁
图片尺寸2592x1936
一滴血检测仪 专业看血液血细胞测血检测非2000倍高清生物显微镜
图片尺寸790x1359
血细胞分析仪ppt
图片尺寸1080x1439
全自动血细胞分析仪crp血常规血液检测仪全程c反应蛋白血球三分类
图片尺寸800x800
沙门氏菌感染患儿外周血细胞形态分析一例
图片尺寸720x928
我的血细胞分析 五分类
图片尺寸1944x2592
各位医生帮我看下血液细胞分析报告,本人看不懂 谢谢
图片尺寸3264x2448
一滴血检测活血形态分析图
图片尺寸1200x1600
血细胞分析的血小板
图片尺寸450x338
血液学细胞形态
图片尺寸1080x845
血细胞分析有几项低下,帮忙看看什么原因,谢谢!
图片尺寸1280x960
血细胞分析白细胞高红细胞低
图片尺寸289x449
p>血细胞分析是一种通过一些 a href="#" data-lemmaid="1025692">
图片尺寸499x330
血细胞分析报告单怎么看
图片尺寸2448x3264
人外周血免疫细胞亚群25色流式全景分析
图片尺寸2305x2687